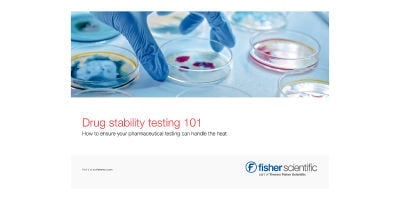
Incubators

Incubators, Ovens, Furnaces, and Environmental Chambers
Providing outstanding temperature uniformity, stability, and reliability.
Thermo Scientific™ microbiological incubators and environmental chambers offer proven features, including outstanding temperature uniformity, stability, and reliability. Our wide portfolio of laboratory ovens and furnaces offers stability and strict temperature control for a full range of needs—from simple glassware drying to the most complex, controlled heating applications.
- Top Categories
- Featured Products
- Microbial Analysis for Quality Control
- Resources
- Contact Us
Top Categories
Featured Products
Catalog Number 10699640
Catalog Number 10590021
Catalog Number 10664142
Catalog Number 15618540
Catalog Number 16421135
Microbial Analysis for Quality Control

Video
Heratherm Microbiological Incubators Overview
Watch this video to learn how our Heratherm microbiological incubators can meet your application needs.
Helpful Resources
Contact Us

Incubators, Ovens, Furnaces, and Environmental Chambers
Providing outstanding temperature uniformity, stability, and reliability.